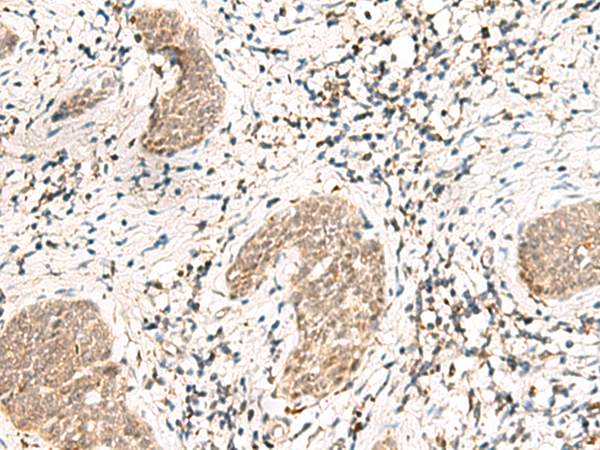
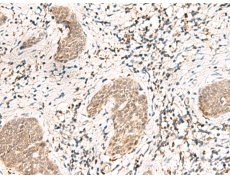
一抗

|
Background: |
The protein encoded by this gene is a component of the U1, U2, U4, and U5 small nuclear ribonucleoprotein complexes, precursors of the spliceosome. The encoded protein may also be a part of the U7 small nuclear ribonucleoprotein complex, which participates in the processing of the 3' end of histone transcripts. Several transcript variants encoding different isoforms have been found for this gene. |
|
Applications: |
ELISA, IHC |
|
Name of antibody: |
SNRPG |
|
Immunogen: |
Synthetic peptide of human SNRPG |
|
Full name: |
small nuclear ribonucleoprotein polypeptide G |
|
Synonyms: |
SMG; Sm-G |
|
SwissProt: |
P62308 |
|
ELISA Recommended dilution: |
5000-10000 |
|
IHC positive control: |
Human esophagus cancer |
|
IHC Recommend dilution: |
30-150 |
購物車
購物車 幫助
幫助
 021-54845833/15800441009
021-54845833/15800441009